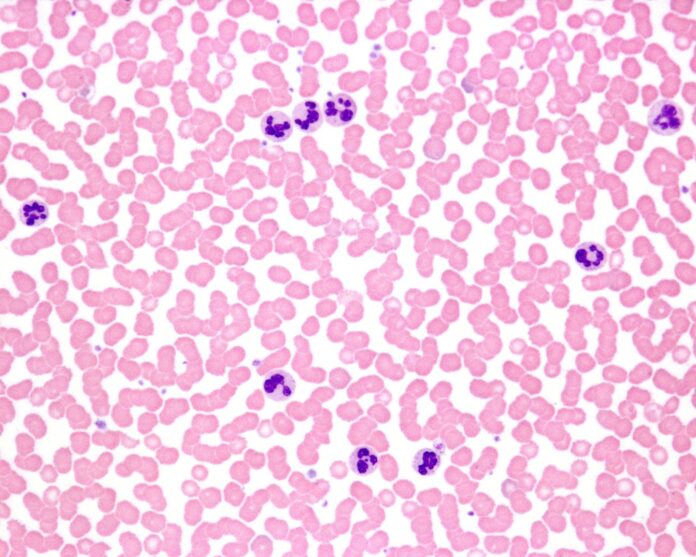
podwyższone leukocyty

Podwyższona liczba leukocytów w morfologii krwi to częsty wynik, który może pojawić się zarówno w trakcie infekcji, jak i po wysiłku, stresie czy po zastosowaniu niektórych leków. Najczęściej odzwierciedla fizjologiczną mobilizację komórek układu odpornościowego lub reakcję na stan zapalny, ale czasem wymaga pogłębionej diagnostyki. W tekście omawiamy, czym jest leukocytoza, jakie są jej najczęstsze przyczyny, jak interpretować wynik w kontekście rozmazu oraz kiedy potrzebna jest pilna konsultacja specjalistyczna.
| Z tego artykułu dowiesz się, że: >> leukocytoza to zwiększona liczba białych krwinek, a interpretacja wyniku zależy od wieku, stanu fizjologicznego (np. ciąży) i norm danego laboratorium, >> za podwyższone leukocyty we krwi przyczyny najczęściej odpowiadają infekcje (zwłaszcza bakteryjne), stany zapalne, stres, wysiłek, palenie tytoniu, otyłość i niektóre leki, >> kiedy warto szybko skonsultować wynik: gdy leukocyty są bardzo wysokie (zwłaszcza >50 000/µl) lub szybko rosną; wartości >100 000/µl zwykle wymagają pilnej oceny hematologicznej, >> w diagnostyce liczy się nie tylko liczba leukocytów, ale też dominujący typ (np. neutrofile), dlatego ważna jest morfologia z rozmazem i ocena rozmazu krwi obwodowej, >> lekko podwyższone leukocyty często bywają przejściowe i wystarcza kontrola oraz ocena trendu w kolejnych badaniach. |
Spis treści:
- Co to jest leukocytoza?
- Jaki poziom leukocytów jest niebezpieczny?
- Podwyższone leukocyty – o czym świadczą?
- Przyczyny leukocytozy
- Podwyższone leukocyty w ciąży
- Lekko podwyższone leukocyty – czy to powód do niepokoju?
- Objawy leukocytozy
- Diagnostyka podwyższonych leukocytów
- Jakie badania wykonać przy podejrzeniu infekcji?
- Jak obniżyć leukocyty we krwi?
- Co jeść, aby obniżyć leukocyty?
- Leukocytoza: odpowiedzi na najczęstsze pytania (FAQ)
Co to jest leukocytoza?
Leukocytoza to stan, w którym liczba leukocytów (białych krwinek, WBC) we krwi jest zwiększona w porównaniu z zakresem uznawanym za prawidłowy dla danej osoby. U dorosłych (poza ciążą) leukocytozę najczęściej definiuje się jako liczbę leukocytów >11 000/µl, ale zakresy referencyjne mogą się różnić między laboratoriami.
Leukocyty nie są jednorodną grupą – należą do nich m.in. neutrofile, limfocyty, monocyty, eozynofile i bazofile. Dlatego w praktyce liczy się nie tylko podwyższony wynik całkowity, ale też obraz odsetkowy i wartości bezwzględne poszczególnych typów krwinek.
>> Zobacz również: Granulocyty i ich rodzaje. Jaką pełnią funkcję?
Jaki poziom leukocytów jest niebezpieczny?
W wielu sytuacjach podwyższone leukocyty to łagodna, przejściowa reakcja organizmu. Są jednak wartości, które powinny skłaniać do pilnej konsultacji i pogłębionej diagnostyki:
- 50 000–100 000/µl – takie wartości mogą występować w ciężkich zakażeniach i silnym stanie zapalnym (tzw. odczyn białaczkowy).
- >100 000/µl – sytuacja, która prawie zawsze wymaga pilnej oceny hematologicznej; najczęściej jest związana z białaczką lub chorobą mieloproliferacyjną.
| Ważne! Sama liczba leukocytów nie jest rozpoznaniem. O pilności postępowania decydują też objawy, czas utrzymywania się leukocytozy i wenig rozmazu. |
Podwyższone leukocyty – o czym świadczą?
Najprościej mówiąc, leukocytoza oznacza aktywację układu odpornościowego i/lub przemieszczenie leukocytów z puli marginalnej oraz rezerw szpikowych do krwi; po silnym bodźcu liczba leukocytów może wzrosnąć nawet w ciągu kilku godzin.
Najczęściej jest to odpowiedź na infekcję lub stan zapalny. Rzadziej leukocytoza bywa związana z chorobami układu krwiotwórczego (procesem klonalnym w szpiku).
Przyczyny leukocytozy
Przyczyny leukocytozy można podzielić na reaktywne (wtórne) oraz pierwotne (klonalne).
Do najczęstszych przyczyn reaktywnych należą:
- infekcje – leukocytoza jest częsta zwłaszcza w zakażeniach bakteryjnych; często dominuje neutrofilia, a w rozmazie może pojawić się tzw. „przesunięcie w lewo” (więcej form młodszych neutrofili),
- stany zapalne i choroby przewlekłe (np. choroby reumatyczne, nieswoiste zapalenia jelit) – leukocytoza może nasilać się w okresach zaostrzeń,
- stres, wysiłek fizyczny, uraz, oparzenia, zabieg operacyjny – mogą wywołać szybki wzrost leukocytów przez mobilizację komórek z puli marginalnej i szpiku,
- leki – m.in. glikokortykosteroidy, β-mimetyki, sole litu, adrenalina oraz czynniki wzrostu kolonii (np. G-CSF),
- palenie tytoniu, otyłość, asplenia (brak śledziony lub jej nieprawidłowa funkcja) – mogą powodować przewlekle podwyższony wynik.
Podejrzenie przyczyny hematologicznej nasila się, gdy leukocytoza jest duża lub utrzymuje się tygodniami, w rozmazie obecne są komórki niedojrzałe, a także gdy współistnieją zaburzenia innych linii krwi (np. niedokrwistość, małopłytkowość lub nadpłytkowość) albo objawy ogólne.
Podwyższone leukocyty w ciąży
W ciąży fizjologicznie może dochodzić do stopniowego wzrostu liczby leukocytów oraz niewielkiego przesunięcia w kierunku neutrofili, szczególnie w późniejszym etapie ciąży. Dlatego u części ciężarnych podwyższona liczba leukocytów może być wariantem normy i powinna być interpretowana w odniesieniu do zakresów referencyjnych danego laboratorium oraz — o ile to możliwe — porównana z wcześniejszymi wynikami pacjentki.
Jeśli jednak podwyższone leukocyty w ciąży współistnieją z gorączką, bólem, objawami dyzurycznymi, kaszlem lub złym samopoczuciem, wymagają oceny w kierunku infekcji i innych przyczyn.
>> Więcej na ten temat przeczytasz w artykule: Podwyższone leukocyty w ciąży – o czym mogą świadczyć?
Lekko podwyższone leukocyty – czy to powód do niepokoju?
Lekko podwyższone leukocyty (np. niewielkie przekroczenie górnej granicy normy) często są przejściowe. Mogą utrzymywać się po niedawnej infekcji, po intensywnym treningu, w sytuacjach stresowych lub u osób palących.
W takich sytuacjach lekarz zwykle ocenia, czy wynik pasuje do objawów i wywiadu, oraz zaleca kontrolne badanie (czasem wraz z rozmazem). Ważny jest trend: czy leukocyty rosną, stabilizują się, czy wracają do normy.
Objawy leukocytozy
Sama leukocytoza często nie daje charakterystycznych objawów — dolegliwości wynikają zwykle z przyczyny, która doprowadziła do wzrostu leukocytów. W infekcji mogą dominować gorączka oraz objawy zależne od lokalizacji zakażenia. W stanach zapalnych przewlekłych typowe są bóle stawów, biegunki, osłabienie.
Warto znać objawy, które mogą sugerować chorobę układu krwiotwórczego i wymagają pilnej konsultacji:
- gorączka >38°C bez jasnej przyczyny,
- niezamierzona utrata masy ciała, nocne poty,
- narastające zmęczenie, łatwe siniaczenie lub krwawienia,
- powiększone węzły chłonne, uczucie pełności w lewym podżebrzu (możliwa splenomegalia).
>> Przeczytaj również: Białaczka (leukemia, rak krwi) – objawy, rodzaje, diagnostyka i leczenie
Diagnostyka podwyższonych leukocytów
Diagnostyka zaczyna się od prostych kroków, które często pozwalają wyjaśnić, o czym świadczą podwyższone leukocyty:
- Potwierdzenie wyniku – powtórzenie morfologii krwi.
- Morfologia z rozmazem – rozmaz (automatyczny i/lub manualny) pokazuje, które leukocyty dominują (np. neutrofile, limfocyty) i czy pojawiają się formy niedojrzałe.
- Ocena rozmazu krwi obwodowej – może ujawnić cechy reaktywne albo sugerujące proces klonalny.
- Wywiad i badanie przedmiotowe – ocena objawów, przyjmowanych leków i czynników ryzyka oraz badanie ukierunkowane m.in. na węzły chłonne i śledzionę.

Jeśli leukocytozie towarzyszą nieprawidłowości innych linii krwi (np. anemia, nieprawidłowe płytki) lub w rozmazie dominują komórki niedojrzałe, zwykle potrzebna jest pilna diagnostyka specjalistyczna.
>> Zobacz również: Co to są niedojrzałe granulocyty i o czym świadczą?
Jakie badania wykonać przy podejrzeniu infekcji?
Zakres badań zależy od objawów i prawdopodobnego ogniska zakażenia. Najczęściej rozważa się:
- CRP i/lubOB (czasem także prokalcytoninę),
- badanie ogólne moczu (a gdy trzeba – posiew),
- badania mikrobiologiczne z ogniska (np. posiew plwociny, wymazy),
- RTG klatki piersiowej przy kaszlu, duszności lub podejrzeniu zapalenia płuc.

Warto pamiętać, że sama leukocytoza bez innych cech ciężkiej infekcji nie przesądza o konieczności posiewów krwi — decyzję podejmuje lekarz na podstawie obrazu klinicznego.
Jak obniżyć leukocyty we krwi?
Najważniejsza zasada postępowania przy podwyższonej liczbie leukocytów brzmi: zwykle nie „leczy się wyniku”, tylko przyczynę. Jeśli powodem jest infekcja, leukocyty często obniżają się po ustąpieniu choroby lub po wdrożeniu leczenia. W przewlekłych stanach zapalnych kluczowa jest kontrola choroby podstawowej.
Jeżeli leukocytoza może mieć związek z lekami (np. sterydami) lub paleniem tytoniu, lekarz ocenia znaczenie tych czynników. U części osób po zaprzestaniu palenia i poprawie masy ciała wynik może stopniowo wracać w stronę normy.
Co jeść, aby obniżyć leukocyty?
Zalecenia żywieniowe nie są leczeniem leukocytozy samej w sobie – podwyższona liczba leukocytów zwykle odzwierciedla reakcję organizmu na bodziec (np. infekcję, stan zapalny, leki) lub chorobę hematologiczną. W praktyce największe znaczenie ma rozpoznanie przyczyny i jej opanowanie. Elementy diety i stylu życia mogą pośrednio wspierać redukcję przewlekłego stanu zapalnego, zwłaszcza u osób z otyłością lub palących.
Leukocytoza: odpowiedzi na najczęstsze pytania (FAQ)
Najczęściej nie — to częsta, przejściowa odpowiedź organizmu na infekcję, stres lub stan zapalny. Niepokój powinny budzić bardzo wysokie wartości, utrzymywanie się leukocytozy przez dłuższy czas oraz objawy ogólne (np. nocne poty, chudnięcie) lub nieprawidłowości w innych parametrach morfologii.
Zwykle szczególną uwagę zwraca leukocytoza >50 000/µl oraz każda sytuacja, w której wynik szybko rośnie albo towarzyszy mu ciężki stan ogólny. Wartości >100 000/µl wymagają pilnej diagnostyki hematologicznej.
Nie ma jednego progu, który sam w sobie „oznacza białaczkę”. Bardzo wysokie wartości (zwłaszcza >100 000/µl) silnie ją sugerują, ale o rozpoznaniu decydują m.in. rozmaz krwi, obecność komórek niedojrzałych (blastów) oraz badania specjalistyczne.
Tak. Silny stres emocjonalny lub fizyczny, intensywny wysiłek, uraz czy zabieg operacyjny mogą w krótkim czasie zwiększyć liczbę leukocytów. Dzieje się tak głównie przez przesunięcie komórek z puli marginalnej do krwi oraz szybkie uwolnienie leukocytów z rezerw szpikowych.
Najczęściej są to infekcje (zwłaszcza bakteryjne), stany zapalne, leki (np. sterydy, β-mimetyki, lit), palenie tytoniu, otyłość, asplenia oraz stres i wysiłek. Rzadziej przyczyną są choroby układu krwiotwórczego.
Bibliografia
- Rupert J., Riley L.K. Ocena pacjentów z leukocytozą. Medycyna Praktyczna (mp.pl). Tłumaczenie artykułu: Evaluation of Patients with Leukocytosis, American Family Physician 2015;92(11):1004–1011.
- van Zuuren E.J., Aird W. Leukocytosis – Approach to the Patient. ClinicalKey.
- Coates T.D. Approach to the patient with neutrophilia. UpToDate.com.